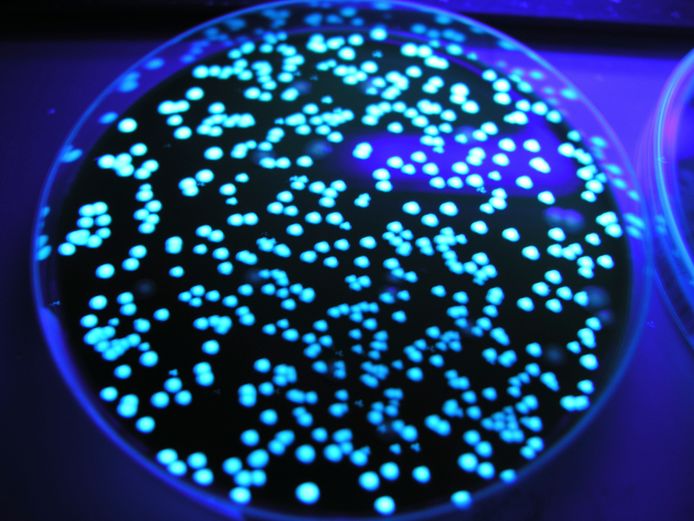

Legionella
K nákaze dochází téměř výhradně. Legionellatartunnan voi saada.

Legionella Risk Management Chem Aqua Nch Europe Nch Europe
Legionella bacteria can also cause a less serious illness called Pontiac fever.

Legionella. Its caused by the bacterium Legionella pneumophila found in both potable and nonpotable water systems. This information will help employers and those with responsibility for the control of premises including landlords understand what their duties are. Legionella bacteria can cause a serious type of pneumonia lung infection called Legionnaires disease.
Legionella je rod patogenních bakterií čeledi Legionellaceae způsobující tzv. Legionellojen aiheuttamat joukkosairastumiset ovat liittyneet hotellien sairaaloiden risteilylaivojen ja yleisötapahtumien vesi- ja ilmastointijärjestelmiin. Each year an estimated 56000 to 113000 people are infected with the Legionella bacteria in the United States.
Legionella er almindelige bakterier i vores vandsystemer men de har generelt lav smitsomhed. Legionellabakteerit voivat lisääntyä vesijärjestelmissä ja kulkeutua aerosolien mukana hengitysilmaan. Legionellabakteerit voivat lisääntyä vesijärjestelmissä ja kulkeutua aerosolien mukana hengitysilmaan.
Legionellat ovat bakteereja joita esiintyy pieniä määriä makeissa luonnon vesissä ja maaperässä. Nogle typer er dog mere smitsomme end andre og kan give årsag til udbrud hvor flere smittes fra samme kilde mens de mest almindelige typer er mindre smitsomme og generelt kun årsag til såkaldte sporadiske enkeltstående tilfælde. Herunder finder du fakta og gode råd om hvordan du undgår legionellabakterier.
Borger Fagperson Legionella - legionærsygdom. Legionellaa esiintyy pieniä määriä makeissa luonnon vesissä ja maaperässä. Legionærsygdom er en lungebetændelse der skyldes den gruppe bakterier som hedder LegionellaNavnet på sygdommen stammer fra det første store udbrud som opstod under en konference for amerikanske krigsveteraner legionærer i Philadelphia i 1976.
Nejvíce infekcí způsobuje druh Legionella pneumophila která postihuje především dýchací cesty. The process of getting rid of the legionella risks in your water systems should always start with a risk assessment under UK health and safety law it is a legal requirement. Legionella pneumophila aiheuttaa legioonalaistaudin eli legionelloosin joka on vakava keuhkokuume.
Nemoc legionářů či mírnější pontiackou horečku. Det smitter ved innånding av fine svevende vanndråper aerosoler som er forurenset med bakteriene. Legionella on aerobisten gramnegatiivisten sauvabakteerien suku.
Legionella eller legionærsygdom blev opdaget sidst i 1970erne hvor sygdommen brød ud som epidemi under en kongres for amerikanske krigsveteraner legionærer - deraf navnet. Legionnaires disease is a severe often lethal form of pneumonia. Legionella è un batterio.
Legionella se obykle vyskytuje a množí v úsadách teplovodních potrubích boilerech a klimatizacích. This website provides practical advice and guidance to control the risks from exposure to Legionella in man made water systems. A legionella risk assessment will highlight any potential dangers and give you guidance on the steps that should be taken to reduce those risks to keep people safe.
Gram-negativo cioè negativo alla colorazione di Gram test relativamente veloce utilizzato per rilevare la presenza ed identificare grossolanamente i batteriLa parete cellulare della Legionella è caratterizzata dalla presenza di acidi grassi a catena ramificata di solito non presenti nei batteri Gram. This fact sheet describes what Legionnaires disease is its symptoms how its spread and treated and who is at increased risk. Temasiden inneholder informasjon om legionella.

Legionella Contamination Via Water Purification Installations Air Liquide Belgium Netherlands Luxembourg Blog

Legionella De Groene Hoed Duurzaam

Legionella Pneumophila Trends In Microbiology
Een Dode Door Legionella Uitbraak In Schijndel Meerdere Patienten In Ziekenhuis Gezond Ad Nl
Aquatreat Industriele Waterbehandeling

Legionella Of Veteranenziekte Gezondheid Be

Legionella Veteranenziekte Uit Urine Bloedwaardentest

Hoe Voorkom Ik Legionella In Huis Ontzorgexperts

Legionella Bacterie Informatie Preventie Dr Engineering

Legionella Wat Is Legionella Aqua Assistance Legionellabeheer En Preventie
Schijndel In Greep Van Legionella Maar Ggd Heeft Geen Idee Waar Bron Van Dodelijke Bacterie Zit Legionella In Schijndel Bd Nl

Legionellabeheersing Legionella Uitbraak Voorkomen

Legionella Analyse Normec Biobeheer
Pathology Of Legionellosis Legionnaires Disease Dr Sampurna Roy Md
Common Source Of Legionella Transmission Download Scientific Diagram